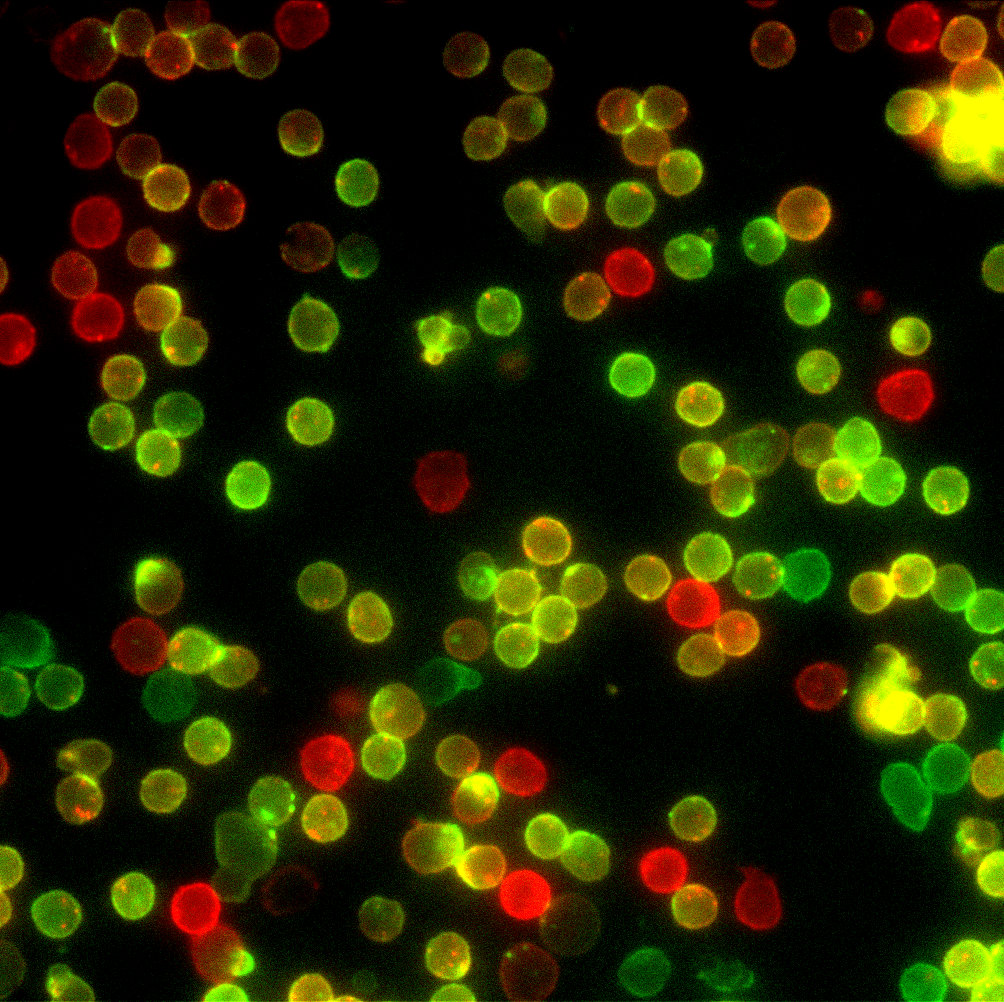

Easily generate publication-quality images at high throughput speeds
The WiScan Hermes from IDEA Bio-medical is a cost-effective High-Content Screening system that operates at extremely high speeds of image acquisition, generating high-quality images.
Hermes is intuitively operated. Its built-in applications are extremely easy to use and are operated at the push-of-a-button. IDEA Bio-Medical’s effective, proprietary analysis software, provides a sophisticated image processing algorithmic library, operated by a unique and simple software interface.
Offering fluorescence colours, bright field option, Laser-based photobleaching and a large range of air objectives, Hermes is a sophisticated and flexible system. The system can accommodate a variety of plates and sample formats.
Hermes’ mechanisms are based on patents, creatively designed to meet heavy-duty operation demands (24/7) with full process robustness.

Versatile
Whether you are performing assay development, compound screens, transfection assays or looking at a few samples in great detail, and whether you are using 3D models (such as spheroids, Organoids), Zebrafish imaging, primary cells, fixed cells or live cell imaging, WiScan® Hermes is the solution for you.
Reliable
WiScan Hermes, IDEA Bio-Medical’s automated imaging system for high content screening (HCS) provides the unique combination of the two contradicting primary functions of automated microscopy: Image quality and acquisition speed.
Robust
WiScan® Hermes’ mechanisms are based on patents, creatively designed to meet heavy duty operation demands (24/7) with full process robustness.
Flexible
WiScan® Hermes is a cost-effective system that is both sophisticated and flexible, offering 7 fluorescence colors, bright field option, and a large range of air objectives. The system can accommodate a variety of multi-well plates and sample formats (slides, dishes…) and offers environmental control for live cell assays.
Intuitive
It doesn’t matter if you are a beginner or an experienced microscopist, Hermes easily allows you to look deeper into your samples. The system is intuitively operated. Its built-in applications are extremely easy to use, and are operated at the push-of-a-button.
Image Gallery

Technology
Patented XYZ Scanner
Patented XYZ scanner with 100nm resolution
- Consists of an optical path for illumination and image acquisition.
- Holds 1 objective at a time – the objective is the moving part while the plate remains stationary.
- Equipped with linear motors and linear encoders for closed loop operation.
Patented Objective Exchanger
- Special patented objective holder enables quick connect manually or automatically of Olympus objectives with no adjustment needed.
- Objective magazine holds 3 objectives.
- Automatic loading of objectives to the scanner.
- Offering 20 nm repeatability in positioning of the loaded objective.


Multi Channel Imaging Module
- The imaging module consists of 1-4 imaging channels
- LED based fluorescence imaging with 2-7 optional wavelengths
- Brightfield using white LED illumination
- Laser based photo bleaching
- Image resolution ranges from 0.1 to 3 µm / pixel 60X-2X objective magnifications
Patented Autofocus
- Patented laser autofocus method with 100nm sample plane detection. Insures highly sharp images for full image segmentation reliability.
- Several algorithms are implemented for optimal performance in various magnifications.
- High throughput mapping for scanning
- U-shaped bottom plates used for spheroids and organoids imaging
Illumination sources
The Hermes is offered with up to 7 fluorescence colours, transmitted white LED light and laser diode used for photo bleaching in FRAP imaging processes. Each of the fluorescence colour combinations is offered with a high/regular screening throughput configuration.
Simultaneous acquisition mode for capturing rapid simultaneous events at maximum acquisition speed, is offered for specific colour combinations.
DAPI
Ex. 390/18 | Em. 440/40
Available in 7 colour and HT 4 colour (included in standard) configurations
CFP
Ex. 438/24 | Em. 482/35
Available in 7 colour, HT 4 colour and HT 3 channel configurations
FITC
Ex. 475/28 | Em. 525/30
Available in 7 colour and HT 4 colour (included in standard) configurations
YFP
Ex. 513/17 | Em. 542/27
Available in 7 colour, HT 4 colour and HT 3 channel configurations
TRITC
Ex. 549/15 | Em. 607/36
Available in 7 colour and HT 4 colour (included in standard) configurations
mCherry
Ex. 575/25 | Em. 624/40
Available in 7 colour, HT 4 colour and HT 3 channel configurations
FITC
Ex. 648/20 | Em. 694/44
Available in 7 colour and HT 4 colour (included in standard) configurations
YFP
635 nm | 5 mW
Available in 7 colour, HT 4 colour and HT 3 channel configurations
Configuration Options

Software

Intuitive, Powerful, Precise
A software tool for application-derived analysis and visualization of image-based experiments.
Analysis platform for the most common cell biology applications. Athena Incorporates embedded analysis algorithms, statistical evaluation tools and sub-population analysis tools, based on advanced cell quantification tools for measuring fluorescence intensity and morphological features.
Athena consists of a library of pre-built analysis modules applied to data sets of both labelled and non-labelled cells, thus Athena is capable of analysing images acquired in bright field and fluorescence illumination microscopy.
All levels of users can be easily trained and use this platform simply and independently. Athena offers a bank of ready-made applications which are loaded by the push of a button and allow the user to start analysis within a few minutes, after performing mild parameter calibrations.
The UI and UX are optimized for analysing image-based cell biology experiments. New comers to high content image analysis can get productive right away using Athena’s pre-configured templates for the most common cell biology applications.

Smart, Modular, Versatile
The WiSoft® Minerva analysis software package offers extremely versatile image processing, segmentation, quantification and multi-parametric statistical analysis, and a variety of image and data visualization tools. The rich set of image analysis functions and modules together with the large repertoire of visualization tools for images and output data are flexibly assembled into an analysis pipeline in a workflow-based interface.
Minerva enables biologists who are non- image analysis experts to develop image analysis scripts on their own. Images can be segmented with just a few clicks of the mouse and then tailored algorithms developed quickly and easily.
Minerva’s modularity enables the adaptation of ready-made analysis modules for specific biological assays, simple programming of analysis scripts using pre-configured image analysis functions, and high-level programming, enabling the addition of algorithms for customized functions.
The workflow-based interface consists of simple navigation through the analysis modules for simple creation of new functions. The software offers flexible input and output formats and a uniform data structure to allow simple merging of functions from external sources.
Easily generate publication-quality images at high throughput speeds